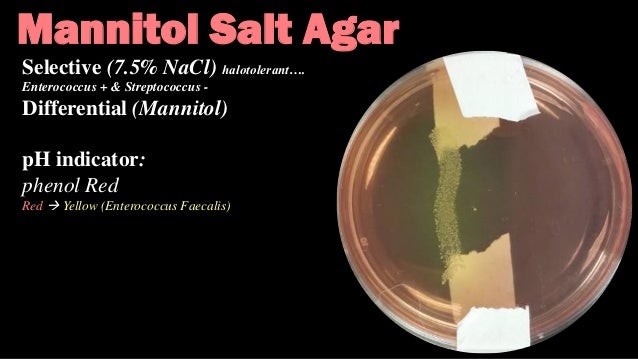
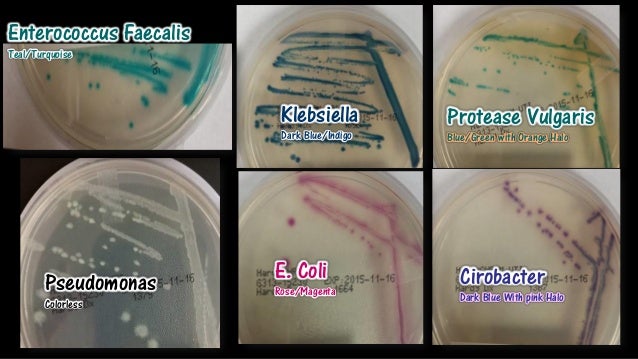
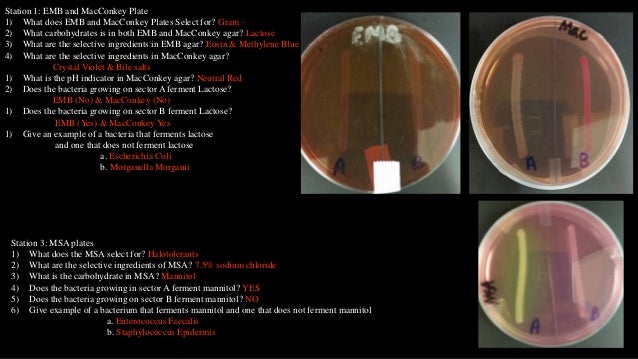

Enterococcus Faecalis Msa Plate

Types Of Microorganisms Media

Vetbact

Pathogenic Bacteria And Identification Microbiology Learning The Why Ology Of Microbial Testing

Microbiology Lab Molb 2210

I Ve Attached Lab Worksheets And Images Phenylet Chegg Com

Mannitol Salt Bacterial Growth Medium Msa Page 2


Microbiology Lab Exercise 10 Selective Enriched And Differential Media Flashcards Cram Com

Microbiology Lab Final Flashcards Quizlet

Microbiology Lab Practical 3 Flashcards Quizlet
2

Micro Lab Practical 3 Flashcards Quizlet

Mannitol Salt Bacterial Growth Medium Msa Page 2

Enterococcus Faecium By Bailey Newman
2

Media Flashcards Quizlet
Microbiology Practical 2 I Will Miss This Class Ilana Kovach

Microbiology Lab Molb 2210
2

Emb Agar

Lab 5 Integumentary System Bacteriology And Identification Ppt Download
Ilovemicrobiology Ilana Kovach

Enterococcus Faecalis Under Microscope Microscopy Of Gram Positive Cocci Morphology And Microscopic Appearance Of Enterococcus Faecalis Enterococcus Faecalis Gram Stain And Colony Morphology On Agar Clinical Significance

100 ร ปภาพท ด ท ส ดในบอร ด Bacteria จ ลช วว ทยา แล บ ช วว ทยาศาสตร

Biochemical Test And Identification Of Enterococcus Faecalis

Solved So I Am Working On Identifying An Unknown Bacteria Chegg Com
Mountainscholar Org Bitstream Handle 500 4773 Lab Manual Unit 6 Pdf Sequence 9 Isallowed Y
Q Tbn 3aand9gctc7 Ti2xazjh Pytcqe3py0 Houdnudgpyptznfs4nnihj Vgr Usqp Cau

Pathogenic Bacteria And Identification Microbiology Learning The Why Ology Of Microbial Testing

How Enterococcus Faecalis Changes The Mannitol Salt Plate

Mannitol Salt Agar Msa Results Theory Youtube

Microbiology Pinner Seo Name S Collection Of 70 Microbiology Ideas
1

Clinical Microbiology Ppt Download

Mannitol Salt Agar Msa Introduction Composition Preparation Uses And

How To Interpret Mannitol Salt Agar Bacterial Growth Medium Youtube

Mannitol Salt Agar Wikipedia

Vetbact

S Aureus And E Faecalis Colonies Obtained By Culturing Them On Download Scientific Diagram

Mannitol Salt Agar Msa Composition Uses And Colony Characteristics Learn Microbiology Online

Final Exam At St Petersburg College Studyblue
StreppneumoPos.jpg)
Bsci 424 Lab Exercises

Microbiology Lab Final Flashcards Quizlet

Microbiology Lab Molb 2210

Gallery Of Bacteria Photo Gallery Of Bacterial Species Images Of Common Medically Important Bacteria

Microbiology Ch 6 Notes At Augusta University Studyblue
2

Emb Agar

Solved With The Pictures Of The Tests Mannitol Salt Mac Chegg Com

Metabolism Physiology And Growth Characteristics Of Cocci Microbiology A Laboratory Experience

Vetbact
Link Springer Com Content Pdf 10 1007 S 012 11 5 Pdf

Microbiology Lab Media Pics Flashcards Quizlet

Lab Quiz 14 15 17 Flashcards Quizlet
Ilovemicrobiology Ilana Kovach

Mannitol Salt Agar Msa Usp For Staphylococcus 15x100mm Plate 10 Pack By Hardy Diagnostics Emerald Scientific

Biomerieux Culture Media Product D Coccosel Agar

Gallery Of Bacteria Photo Gallery Of Bacterial Species Images Of Common Medically Important Bacteria

Microbiology Bacteria Flashcards Quizlet

Figure 2 From Enterococcus Faecalis Can Be Distinguished From Enterococcus Faecium Via Differential Susceptibility To Antibiotics And Growth And Fermentation Characteristics On Mannitol Salt Agar Semantic Scholar

When The Professor Says You Can Swab Anything For Your Msa Plate Microbiology

Use Of Differential Selective And Enriched Media Microbiology In Review

Media Types Microbiology Learning The Why Ology Of Microbial Testing
1

Metabolism Physiology And Growth Characteristics Of Cocci Microbiology A Laboratory Experience

Vetbact

Mannitol Salt Agar Msa Mycrobe

Summary Of Bi 101j Gen Bio Unseen Life On Earth Su Stearns

Vetbact

Macconkey Agar Youtube

Differential Selective Media Chemical Control Antibiotics Flashcards Quizlet

Mannitol Salt Agar Msa Composition Uses And Colony Characteristics Learn Microbiology Online

Unknown Identification Microbiology Resource Center Truckee Meadows Community College
Link Springer Com Content Pdf 10 1007 S 012 11 5 Pdf

Vetbact

Microbiology Lab Molb 2210
RxnsforGrpABeta-HemoStrep.jpg)
Bsci 424 Lab Exercises

Metabolism Physiology And Growth Characteristics Of Cocci Microbiology A Laboratory Experience

Module 2 Gram Positive Cocci Ppt Download

Ilovemicrobiology Ilana Kovach

Vetbact

The Unknown Is Enterococcus Faecalis The Picture A Chegg Com
Q Tbn 3aand9gcss4zzlcybn Pwzst4faz4kyoeqkqe3fw1pvgjl4lq Usqp Cau

Enterococcus Faecalis Under Microscope Microscopy Of Gram Positive Cocci Morphology And Microscopic Appearance Of Enterococcus Faecalis Enterococcus Faecalis Gram Stain And Colony Morphology On Agar Clinical Significance

Pathogenic Bacteria And Identification Microbiology Learning The Why Ology Of Microbial Testing

Mannitol Salt Agar Msa Plate
2

Methicillin Resistant Staphylococcus Aureus Vancomycin Resistant Enterococcus Faecalis And Enterococcus Faecium Active Dimeric Isobutyrylphloroglucinol From Ivesia Gordonii Pdf Download Free
How Enterococcus Faecalis Changes The Mannitol Salt Plate

Ilovemicrobiology Ilana Kovach

Selective And Diff Media List

Growth On Mannitol Salt Agar Media Showing Presence Of Yellow Halo Download Scientific Diagram

Mannitol Salt Bacterial Growth Medium Msa Page 2

Ilovemicrobiology Ilana Kovach

Microbiology Lab Molb 2210

Microbiology Selective Differential Plates Lab Flashcards Quizlet

How Enterococcus Faecalis Changes The Mannitol Salt Plate

Mannitol Salt Bacterial Growth Medium Msa Page 2

Emb Levine Agar Eosin Methylene Blue For Culture Of Gram Negative Bacteria 15x100mm Plate 10 Pack By Hardy Diagnostics Emerald Scientific
Msa Quora
Mountainscholar Org Bitstream Handle 500 4773 Lab Manual Unit 6 Pdf Sequence 9 Isallowed Y

Biomerieux Culture Media Product Granadatm Agar Columbia Cna 5 Sheep Blood
Jcm Asm Org Content 47 9 2802 Full Pdf
2

Microbiology Pinner Seo Name S Collection Of 70 Microbiology Ideas